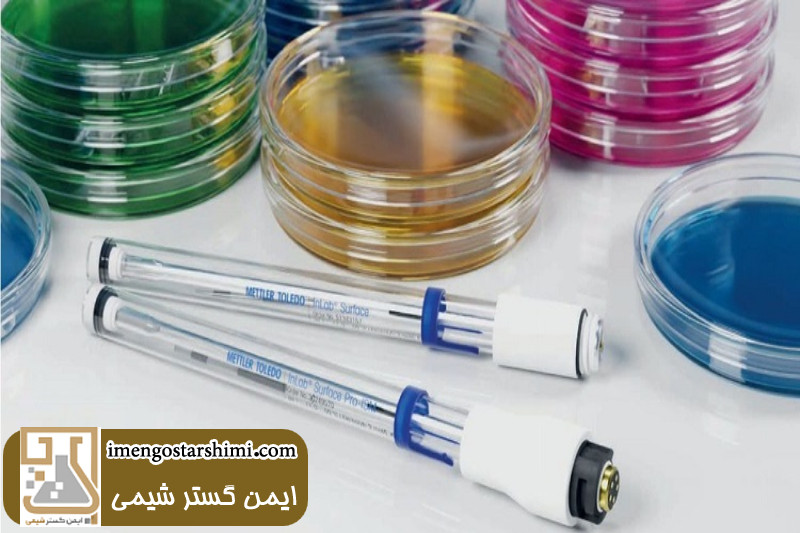

پلیت آزمایشگاهی یکی از تجهیزات آزمایشگاهی ضروری در آزمایشگاه های تحقیقاتی، آموزشی، صنعتی و تشخیص طبی است. این وسیله در فرآیند هایی مانند کشت سلول، کشت میکروبی، آزمایش های شیمیایی و بررسی نمونه ها کاربرد دارد. پلیت ها در انواع مختلف از جمله پلیت پلاستیکی، پلیت شیشه ای، پلیت استریل و پلیت یک بار مصرف تولید می شوند. انواع مختلف پلیت ها از نظر جنس، ظرفیت و تعداد خانه ها متفاوت هستند. مدل های محبوب شامل پلیت 6 خانه، پلیت 24 خانه و پلیت 96 خانه می باشند. انتخاب صحیح نوع پلیت برای موفقیت آزمایش های مختلف اهمیت زیادی دارد. شناخت تفاوت های مدل ها، برند های معتبر و آگاهی از قیمت پلیت آزمایشگاهی برای انتخاب بهینه ضروری است. در ادامه به معرفی انواع پلیت ها و نکات خرید آن ها خواهیم پرداخت.

پلیت آزمایشگاهی یا پتری دیش ظرفی دایره ای شکل و کم عمق است که معمولا از شیشه یا پلاستیک شفاف ساخته می شود و به صورت استریل در اختیار کاربران آزمایشگاهی قرار می گیرد. این وسیله یکی از اصلی ترین ابزار ها برای کشت میکروارگانیسم ها، بررسی واکنش های زیستی و انجام آزمایش های میکروبی و سلولی به شمار می رود. پلیت آزمایشگاهی معمولا شامل یک درب هم اندازه است که از ورود آلودگی به محیط کشت جلوگیری می کند. این پلیت ها به دلیل طراحی ساده و کارایی بالا، در طیف گسترده ای از فعالیت های تحقیقاتی، پزشکی و دارویی مورد استفاده قرار می گیرند. پلیت کشت میکروبی با استفاده از محیط های کشت مناسب، بستری ایده آل را برای رشد باکتری ها، قارچ ها و سایر میکروارگانیسم ها فراهم می آورد. همچنین در مطالعات پیش بالینی برای آزمایش واکنش سلول ها نسبت به داروها و مواد شیمیایی آزمایشگاهی نیز از پلیت کشت سلول استفاده می شود. بسته به نوع کاربرد، پلیت آزمایشگاهی در مدل های مختلفی مانند پلیت 6 خانه، پلیت 24 خانه و پلیت 96 خانه تولید می شود و با توجه به نیاز آزمایشگاه می توان از پلیت یک بار مصرف، پلیت استریل و پلیت مقاوم به دما بهره گرفت. تفاوت در جنس (پلاستیکی یا شیشه ای) و ظرفیت، عامل مهمی در انتخاب مناسب ترین گزینه برای هر آزمایش است.
از مهم ترین انواع کاربردهای پلیت آزمایشگاهی می توان به موارد زیر اشاره کرد:
- کشت میکروبی: یکی از کاربرد های اصلی پلیت آزمایشگاهی، کشت باکتری، قارچ و سایر میکروارگانیسم ها است. در این روش، محیط کشت درون پلیت ریخته شده و پس از جامد شدن، نمونه مورد نظر روی آن تلقیح می شود. پس از مدتی، رشد میکروارگانیسم ها قابل مشاهده و تحلیل خواهد بود.
- کشت سلول: در پلیت کشت سلول، از سطح استریل شده برای رشد سلول های انسانی یا حیوانی استفاده می شود. این پلیت ها معمولا پوشش دار هستند و در تحقیقات ژنتیک، دارویی و سرطان شناسی به کار می روند.
- تست آنتی بیوگرام: در این تست، پلیت حاوی محیط کشت، باکتریایی است و دیسک های آنتی بیوتیک روی آن قرار داده می شوند. نواحی بدون رشد، نشان دهنده اثربخشی آنتی بیوتیک هستند.
.jpg)
- بررسی واکنش زیستی: پلیت ها در آزمایش های آنزیمی و بررسی سمیت مواد شیمیایی کاربرد دارند. استفاده از پلیت مقاوم به دما در این موارد ضروری است.
- شناسایی میکروارگانیسم ها: در آزمایشگاه های تشخیص طبی، برای تشخیص سریع نوع بیماری از پلیت استفاده می شود.
- تحقیقات دارویی و آموزشی: در تحقیقات و آموزش، پلیت برای بررسی تاثیر دارو ها و آموزش روش های کشت و مشاهده نمونه ها کاربرد دارد.
- پلیت پلاستیکی آزمایشگاهی: ساخته شده از پلی استایرن شفاف، سبک، مقرون به صرفه و معمولا یک بار مصرف است.
- پلیت شیشه ای آزمایشگاهی: قابل اتوکلاو، مقاوم به دما و مناسب برای استفاده های چند باره در شرایط استریل.
- پلیت شفاف و مات: پلیت شفاف برای آزمایش هایی که نیاز به بررسی نوری دارند مناسب است. در حالی که پلیت مات برای آزمایش هایی که حساس به نور هستند استفاده می شود.
- پلیت استریل و غیر استریل: پلیت های استریل برای کاربردهای حساس مثل کشت سلول و آزمایش های میکروبی مورد استفاده قرار می گیرند. پلیت غیر استریل معمولا در آزمایش های عمومی یا آموزشی به کار می رود.
- پلیت یک بار مصرف: برای جلوگیری از آلودگی متقاطع در کشت های میکروبی یا سلولی استفاده می شود.
.jpg)
- پلیت 6 خانه: دارای 6 چاهک مجزا برای کشت همزمان چند نمونه با حجم بالا.
- پلیت 24 خانه: مناسب برای آزمایش های مقایسه ای با نمونه های متوسط.
- پلیت 96 خانه: استاندارد در تحقیقات دارویی و بیولوژیک با حجم کم و تکرار بالا.
- پلیت الایزا: این پلیت ها مخصوص آزمایش الایزا هستند و معمولا دارای ۹۶ چاهک می باشند. هر چاهک به عنوان یک واحد آزمایشی عمل می کند و برای سنجش غلظت مواد مختلف از جمله آنتی بادی ها و آنتی ژن ها به کار می رود.
- پلیت مقاوم به دما: مناسب برای آزمایش هایی که نیاز به حرارت دهی یا انکوباسیون در دماهای خاص دارند.
- پلیت کشت سلول: دارای سطح اصلاح شده برای تسهیل چسبندگی و رشد سلول های جانوری یا انسانی.
- پلیت کشت میکروبی: طراحی شده برای نگهداری محیط های کشت جامد مانند آگار برای رشد میکروارگانیسم ها.
- دقت بالا در انجام آزمایش ها: پلیت آزمایشگاهی به دلیل طراحی دقیق و ساختار یکنواخت، امکان انجام آزمایش ها با دقت بالا را فراهم می کند. این ویژگی باعث کاهش خطا های انسانی و افزایش اعتبار نتایج می شود.
- قابلیت انجام آزمایش های همزمان: با استفاده از پلیت های چند خانه مانند پلیت ۹۶ خانه، می توان چندین نمونه را به صورت همزمان آزمایش کرد. این ویژگی در صرفه جویی زمان و منابع بسیار موثر است.
- مناسب برای حجم کم نمونه: پلیت ها برای آزمایش هایی با حجم کم مواد طراحی شده اند. این موضوع علاوه بر کاهش مصرف مواد، باعث کاهش هزینه ها نیز می شود.
- سهولت در مشاهده و تحلیل نتایج: سطح صاف و شفاف بعضی از پلیت ها، امکان مشاهده مستقیم رشد میکروارگانیسم ها یا تغییرات واکنش را فراهم می کند. همچنین تحلیل نتایج با استفاده از تجهیزات نوری آسان تر می شود.
- قابلیت استفاده در دستگاه های خودکار: بسیاری از پلیت های استاندارد قابلیت استفاده در دستگاه های آنالیز خودکار را دارند. این موضوع باعث تسریع روند آزمایش ها و کاهش دخالت دستی می شود.
- تنوع بالا در انواع و کاربرد ها: پلیت آزمایشگاهی در مدل ها و اندازه های مختلف برای کاربرد های متنوعی مثل کشت سلول، کشت میکروبی و آزمایش های آنزیمی تولید می شود. این تنوع باعث می شود در اغلب حوزه های علمی قابل استفاده باشد.
- کاهش احتمال آلودگی: بسیاری از پلیت ها به صورت استریل یا یک بار مصرف عرضه می شوند. این موضوع نقش مهمی در کاهش آلودگی متقاطع، به ویژه در کشت سلول یا کشت باکتری دارد.
- سازگاری با تجهیزات آزمایشگاهی اتوماتیک: به دلیل طراحی استاندارد، بسیاری از پلیت ها با تجهیزات پیشرفته مانند دستگاه الایزا، انکوباتور و میکروسکوپ معکوس سازگار هستند. این ویژگی در آزمایش های تشخیص طبی و دارویی اهمیت بالایی دارد.
- استریلیزاسیون با استفاده از اتوکلاو: یکی از رایج ترین روش ها برای استریل کردن پلیت آزمایشگاهی، استفاده از دستگاه اتوکلاو است. در این روش، پلیت ها در دمای 121 درجه سانتی گراد و فشار 15 پوند بر اینچ (psi) به مدت 15 تا 30 دقیقه قرار می گیرند. این فرآیند به طور مؤثری تمامی باکتری ها، ویروس ها و سایر میکروارگانیسم ها را از بین می برد. این روش برای پلیت شیشه ای آزمایشگاهی و پلیت هایی که توانایی تحمل دما و فشار بالا را دارند، مناسب است.
- استریل کردن با استفاده از اشعه ماوراء بنفش (UV): برای پلیت های پلاستیکی آزمایشگاهی که حساس به دما هستند، استفاده از اشعه UV یک گزینه مناسب است. در این روش، پلیت ها تحت تابش اشعه ماوراء بنفش قرار می گیرند تا میکروب ها و آلودگی های سطحی را از بین ببرند. این روش معمولا برای پلیت یک بار مصرف یا پلیت هایی که نیاز به استریلیزاسیون سریع دارند، استفاده می شود.
- استریل کردن با استفاده از گاز اتیلن اکساید: این روش برای پلیت های حساس به حرارت، مانند پلیت های پلاستیکی که ممکن است در معرض دمای بالا آسیب ببینند، مناسب است. گاز اتیلن اکساید به عنوان یک گاز بی خطر و مؤثر برای از بین بردن میکروارگانیسم ها استفاده می شود. این گاز از طریق نفوذ به پلاستیک، تمام آلودگی ها را از بین می برد و پس از فرآیند، پلیت ها به مدت چند ساعت باید تهویه شوند.
- استریل کردن با استفاده از محلول های شیمیایی: در برخی موارد خاص، برای استریل کردن پلیت آزمایشگاهی از محلول های شیمیایی مانند الکل ایزوپروپیل یا هیدروژن پراکسید استفاده می شود. پلیت ها باید ابتدا با دقت به کمک این محلول ها شسته شوند و سپس با استفاده از جریان هوای تمیز خشک شوند. این روش معمولاً برای استریل کردن پلیت های پلاستیکی آزمایشگاهی که در اتوکلاو قابل استفاده نیستند، به کار میرود.
- استریل کردن با استفاده از حرارت خشک: این روش برای پلیت های شیشه ای آزمایشگاهی مناسب است که تحمل دماهای بالا را دارند. در این روش، پلیت ها در دمای 160 تا 180 درجه سانتیگراد به مدت 2 ساعت در فر یا دستگاه استریل حرارت خشک قرار می گیرند تا تمامی میکروب ها از بین بروند. این روش معمولاً برای پلیت های شیشه ای که می توانند در برابر دما های بالا مقاوم باشند، استفاده می شود.
- انتخاب جنس پلیت: پلیت ها از دو جنس پلاستیک و شیشه تولید می شوند. شیشه ای برای دمای بالا و پلاستیکی برای کاربرد های معمول مناسب است.
- توجه به ظرفیت پلیت: ظرفیت های مختلف مانند پلیت 6 خانه، پلیت 24 خانه و پلیت 96 خانه باید بر اساس تعداد نمونه های مورد نظر انتخاب شوند.
- بررسی استریل بودن پلیت: برای آزمایش های حساس، از پلیت های استریل یا پلیت یک بار مصرف استفاده شود تا از آلودگی جلوگیری شود.
.jpg)
- مقاومت به دما: در کشت میکروبی یا سلولی، پلیت مقاوم به دما انتخاب شود تا محیط کشت در دما های مختلف حفظ گردد.
- کیفیت و برند تولید کننده: برند های معتبر، پلیت های با دوام و مقاوم تری تولید می کنند که از بروز خطا در آزمایش جلوگیری می نماید.
- بررسی قیمت پلیت آزمایشگاهی: قیمت باید متناسب با کیفیت باشد. قیمت بالاتر لزوماً نشانه کیفیت بهتر نیست؛ مقایسه برند ها و بررسی فروشگاه های اینترنتی معتبر اهمیت دارد.
- جنس پلیت: پلیت پلاستیکی ارزان تر از پلیت شیشه ای است. پلیت های شیشه ای به دلیل مقاومت بالا و فرآیند تولید پیچیده، قیمت بیشتری دارند.
- ظرفیت پلیت: هر چه تعداد چاهک ها بیشتر باشد، قیمت پلیت بالاتر می رود. مثلا پلیت ۹۶ خانه گران تر از پلیت ۶ خانه است.
- ویژگی های خاص: پلیت هایی با ویژگی هایی مثل استریل بودن، مقاومت به حرارت یا مناسب برای کشت سلول، قیمت بیشتری دارند.
- برند و کیفیت ساخت: برند های معتبر که پلیت با دوام و دقیق تولید می کنند، قیمت بالاتری دارند اما کیفیت بالاتری نیز ارائه می دهند.
- حجم خرید: خرید عمده باعث کاهش قیمت می شود، در حالی که خرید تکی هزینه بیشتری دارد.
- محل خرید: خرید از فروشگاه اینترنتی معتبر یا نمایندگی رسمی نظیر شرکت ایمن گستر شیمی می تواند قیمت های متفاوتی نسبت به فروشگاه های محلی داشته باشد.
1. آیا پلیت های پلاستیکی برای کشت سلول مناسب هستند؟
پلیت های پلاستیکی معمولاً برای کشت سلول مناسب نیستند مگر اینکه سطح آنها اصلاح شده باشد. برای کشت سلول های حساس، پلیت های شیشه ای بهتر هستند.
2. چه نوع پلیت برای آزمایش های کشت میکروبی مناسب است؟
برای کشت میکروبی، پلیت های پلاستیکی آزمایشگاهی با ظرفیت های مختلف مانند پلیت 6 خانه یا پلیت 24 خانه استفاده می شوند.
3. آیا می توان از پلیت شیشه ای برای آزمایش های دما بالا استفاده کرد؟
بله، پلیت های شیشه ای به دلیل مقاومت در برابر حرارت برای آزمایش های دما بالا بسیار مناسب هستند.
4. تفاوت پلیت پلاستیکی و شیشه ای چیست؟
پلیت های پلاستیکی ارزان تر و یک بار مصرف هستند، در حالی که پلیت های شیشه ای قابل استفاده مجدد و مقاوم به دما هستند.
5. چطور می توان پلیت آزمایشگاهی را استریل کرد؟
پلیت های آزمایشگاهی می توانند با اتوکلاو، اشعه UV، گاز اتیلن اکساید یا محلول های شیمیایی استریل شوند.
6. چرا باید پلیت آزمایشگاهی استریل شود؟
استریلیزاسیون پلیت آزمایشگاهی به جلوگیری از آلودگی میکروبی و افزایش دقت نتایج آزمایش کمک می کند.
آدرس: تهران ، اتوبان چمران جنوب - نرسیده به میدان توحید- باقرخان غربی -پلاک ۱۰۱ - واحد ۳
شما میتوانید با تماس با کارشناسان ایمن گستر شیمی از مشاوره رایگان استفاده کرده و ما به صورت کامل پاسخگوی سوالات شما عزیزان هستیم ، همچنین اگر کالای خاصی مد نظر شما باشد در تهیه آن شما را راهنمایی کنیم .